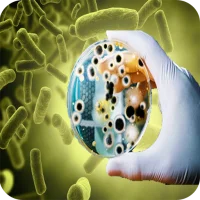

Internet
Loading...
More »










Popular Apps

Shape FoldBikas

GS Auto Nissan Connectikon Technologies

Adobe Acrobat Reader: Edit PDFAdobe

Forward: Escape The FoldChristophe Coyard

Messages - SMS Texting AppBattery Stats Saver

Bluetooth Volume Managerdarken

Action for Happiness: Get TipsAction for Happiness

ThreadsInstagram

Volume ManagerByteHamster

Discord - Talk, Play, Hang OutDiscord Inc.
More »










Editor's Choice

SigmaSigma Platform

Committees - AvenuesVladimir Semakov

Comma CommunityMighty Networks

Merge and HookKobGames

T-Mobile Scam ShieldT-Mobile USA

SaveMyTime - Time TrackerSave My Time

LED Banners - Text ScrollerAloha Std

HeavenBurnsRedYostar Limited.

Bingo HeavenAlitechnalogy

heaven travelyanSquareHeaven